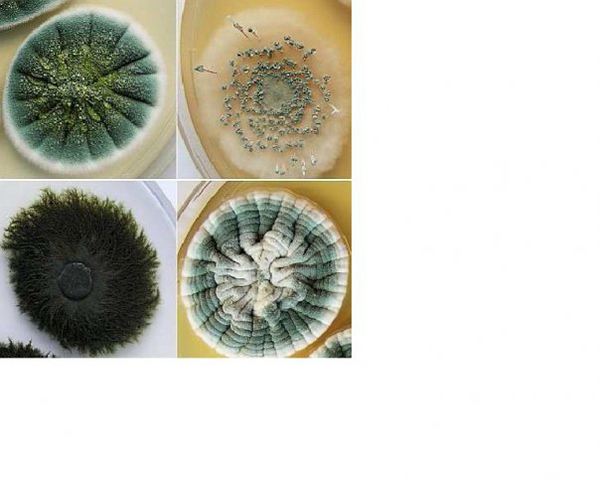
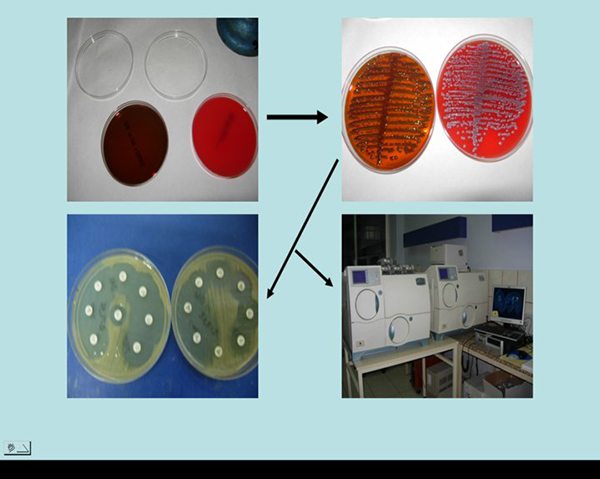

Kültür Laboratuvarı
Yapılan tetkiklerin listesi
İdrar,kan,üst solunum yolu örneÄŸi,alt solunum yolu örneÄŸi,dışkı rektal sürüntü,genital sistem örneÄŸi,beyin omirilik sıvısı,deri,kazıntı,yumÅŸak doku biyopsi ve steril boÅŸluk örneklerinin bakteri mantar ve tüberküloz yönünden kültürleri yapılmaktadır.Bunun dışında bazı örneklerin moleküler düzeyde incelemeleride bu laboratuvarda gerçekleÅŸtirilmektedir.
Laboratuvar iletiÅŸim bilgileri ve hastane içindeki yeri
Sekreterler: 3303-3001 ( mikrosek@mail.ege.edu.tr)
Bakteriyoloji Lab no : 3010-3011
Seroloji Lab no : 3303-3304
Mikobakteriyoloji Lab no : 3006-3007
Mikoloji Lab no : 3008
Nöbet odası (doktor) : 3020
Nöbet odası (teknisyen) : 30